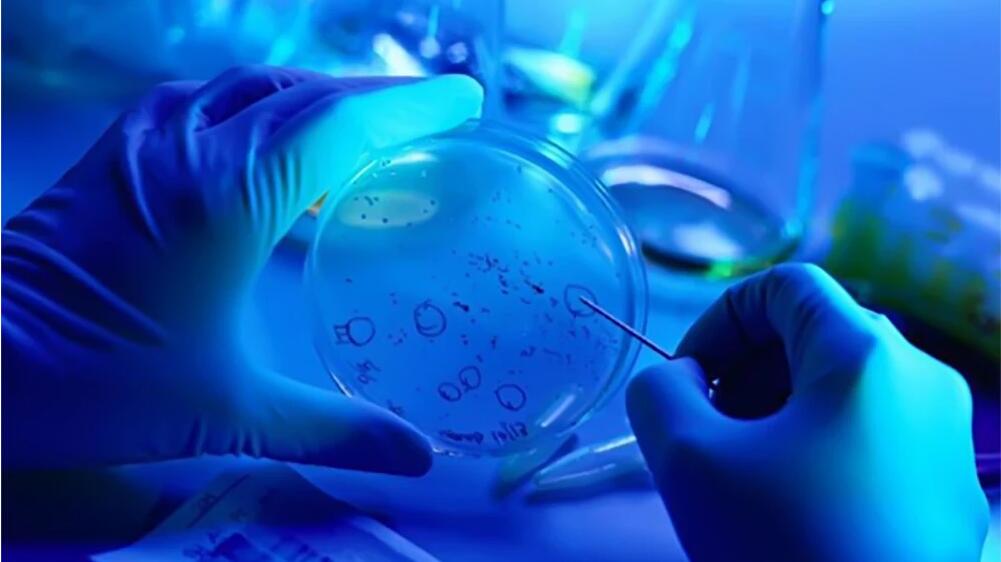

CAR-T细胞治疗药物的问世,给不少血液肿瘤患者带来福音。记者11日获悉,奕凯达( 阿基仑赛注射液)用于治疗复发/难治性非霍奇金淋巴瘤(r/r NHL)的中国患者多中心真实世界研究数据“面世”。相关研究在全国17个认证治疗中心纳入患者,数据结果显示,中国患者12个月总生存率高达84.3%,最佳总缓解率达83.2%,最佳完全缓解率为58.4%,且安全性更好。
据悉,CAR-T细胞治疗产品不仅为临床治疗提供了更多选择,更让原本“无药可治”的患者看到了治愈的可能,重获回归正常生活的机会。奕凯达是一种CAR-T细胞治疗药物。
华中科技大学同济医学院附属协和医院梅恒教授当日接受采访时告诉记者,从实现2030健康中国发展目标和老龄社会快速到来两个角度讲,淋巴瘤都是非常需要管理的疾病。它是血液系统的第一大肿瘤,但传统疗法近30年来缺少突破,超过1/3的患者急需新疗法。
“目前以CAR-T为代表的新兴治疗手段逐渐走向临床。”苏州大学附属第一医院吴德沛教授接受记者采访时表示,传统治疗手段不能满足所有淋巴瘤患者的治疗需求,以弥漫大B细胞淋巴瘤为例,有40%的患者不能治愈。中国医学科学院血液病医院邹德慧教授介绍,对于二线复发难治的大B细胞淋巴瘤,既往传统治疗有效率仅略高于20%,而CAR-T的疗效提升巨大。
在第八届上海国际淋巴肿瘤高峰论坛暨第四届国家血液转化和创新论坛上,上海交通大学医学院附属瑞金医院王黎教授介绍了奕凯达中国真实世界中治疗复发/难治性非霍奇金淋巴瘤患者的疗效和安全性数据。据悉,这是基于中国人群CAR-T治疗的真实数据。
据悉,在相关研究中,奕凯达疗效数据与海外真实世界研究ZUMA-1数据以及国际血液骨髓移植研究中心(CIBMTR)数据保持一致。今年六月,该真实世界研究结果已被第28届欧洲血液学协会大会(EHA)年会和第17届恶性淋巴瘤国际会议(17-ICML)两个顶级国际学术会议接收。
浙江大学医学院附属第二医院钱文斌教授对记者表示,中国人群真实世界研究证明了CAR-T用于治疗难治复发的非霍奇金淋巴瘤中国患者的疗效跟国际上相当。随着CAR-T疗法技术进步,国内未来很可能在实体瘤,比如胃癌等治疗领域,形成突破。
南方医科大学珠江医院李玉华教授介绍,在其所在医院,医生们在使用阿基仑赛注射液时致力找到以CAR-T为中心的高危淋巴瘤的治愈策略,让患者高质量地被治愈,高质量地生存,快速回归社会和家庭。梅恒教授则指出,多种CAR-T疗法正在带来治疗上的突破。未来如果奕凯达再往前推进到1.5线疗法,长期生存或会提升至60%-70%,这就达到了临床目的。